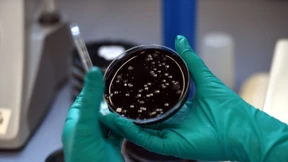
19 Menschen sterben bei großem Legionellenausbruch

Ständige Impfkommission hat neuen Vorsitzenden
Die Ständige Impfkommission ist spätestens seit der Corona-Pandemie den meisten Menschen ein Begriff. Nun gab es personelle Veränderungen. Eines der bekanntesten Gesichter ist nicht mehr dabei.

Die Ständige Impfkommission ist spätestens seit der Corona-Pandemie den meisten Menschen ein Begriff. Nun gab es personelle Veränderungen. Eines der bekanntesten Gesichter ist nicht mehr dabei.

So wie Wettervorhersagen vor Regen warnen können, helfen Pollenprognosen gegen Heuschnupfen-Attacken im Frühjahr. Viele Anbieter nutzen allerdings dieselbe Quelle. Wie zuverlässig ist sie?

Sitzen macht krank: Das bestätigen Daten der KKH Kaufmännischen Krankenkasse. Demnach ist die Zahl der Heranwachsenden, die unter motorischen Entwicklungsstörungen leiden, seit 2012 um 44 Prozent gestiegen.

Säuglinge sollen fortan gegen Meningokokken B geimpft werden. Eine Erkrankung ist zwar sehr selten - aber für Kleinkinder besonders gefährlich.

Geflüchtete Menschen haben nur eingeschränkten Zugang zum Gesundheitssystem. Laut einer Studie sind sie seltener beim Zahnarzt als die Allgemeinbevölkerung. Auch in anderen Medizinbereichen sind sie unterversorgt.

Während das Corona-Geschehen nachlässt, nehmen Grippeerkrankungen in Deutschland zu. Seit Saisonbeginn sind mehr als 30.000 im Labor bestätigte Fälle an das Robert Koch-Institut gemeldet worden. Betroffen seien alle Altersgruppen.

Die HPV-Impfung schützt Frauen vor Gebärmutterhalskrebs, sie ist aber auch für Männer aus mehreren Gründen sinnvoll. Doch die Zahl der Erstimpfungen ist deutlich gesunken.

Im ersten Pandemieherbst und -winter ließen sich fast 50 Prozent mehr Menschen gegen Influenza impfen als im Vorjahr. Seitdem nahmen die Zahlen ab. Selbst in der laufenden Grippewelle kann eine Impfung noch Sinn ergeben.

Viele Menschen in Deutschland waren zuletzt krank. Nun hat das Robert-Koch-Institut den Start der Grippesaison offiziell ausgerufen. Auffällig ist: Viele Kinder und junge Erwachsene sind betroffen.

Schnupfennasen in vielen Familien und Firmen: Infektiologin Susanne Herold über das Ausmaß der Krankheitswelle, die Flucht von Coronaviren vor der Immunabwehr und den verbreiteten Verzicht auf Masken.

In der Erkältungszeit leiden viele unter Fieber. Das ist eigentlich eine Wunderwaffe des Immunsystems. Doch ab wann ist die Körpertemperatur wirklich zu hoch?

HIV ist in der Ukraine noch immer ein großes Problem. Der Krieg erschwert die Versorgung Infizierter und zwingt viele zur Flucht – auch nach Deutschland. Doch eine längere Therapieunterbrechung kann lebensgefährlich sein.

Olaf Scholz reist zum Klimagipfel nach Dubai, Slowaken blockieren die Grenze zur Ukraine – und Experten warnen zum Welt-Aids-Tag vor einer neuen Ausbreitung. Der F.A.Z.-Frühdenker mit allem, was heute wichtig wird.

Gegenwind für den Gesundheitsminister: An den Plänen von Karl Lauterbach für das neue Präventions-Bundesinstitut gibt es scharfe Kritik. Dazu steht die Ständige Impfkommission vor einem Umbruch – die meisten Mitglieder sollen ausgetauscht werden.

Geschlechtskrankheiten treten immer häufiger auf – nicht nur in Deutschland. Ein Grund dafür könnte auch das Dating-Verhalten von jungen Menschen sein.

Covid hat seinen Schrecken verloren. Doch die Wirtschaft ist wachsam. Für eine neue Pandemie lägen die Notfallpläne bereit.

Eine Impfung kann Jungen und Mädchen vor bestimmten Krebsarten bewahren, doch laut der Auswertung einer Krankenkasse nutzen immer weniger diesen Schutz. Ärzte sind besorgt.

Viele Infektionen, wenig Furcht: In diesen herbstlich-nassen Tagen bekommt der Erreger wieder Aufwind. Wie die Bevölkerung nach der Pandemie zu einer Koexistenz mit dem Virus findet.

Im Vergleich zum Vorjahr sind die Todesfälle zurückgegangen. Dennoch waren auch in diesem Jahr Menschen über 85 Jahren besonders gefährdet.

Die Bundesregierung will die Prävention und Kommunikation zu Gesundheitsfragen reformieren und ein neues Bundesinstitut für öffentliche Gesundheit gründen. Eine wichtige Personalie steht schon fest, unklar bleibt die Strategie.

Eine Corona-Impfung sei der beste Schutz vor schweren Krankheitsverläufen, sagt Gesundheitsminister Karl Lauterbach. Er rät Menschen über 60 und solchen mit Risikofaktoren zur Auffrischung.

Das Gesundheitssystem wird wegen Corona und anderer Erreger im Herbst stark belastet, sagen Fachleute. Nun steht erst einmal ein neuer Impfstoff zur Verfügung.

Die Kliniken im Rhein-Main-Gebiet beobachten die Corona-Lage genau. Noch entscheiden aber alle selbst, welche Regeln bei ihnen gelten sollen.

Die Temperaturen in diesem Sommer haben bisherige Höchstwerte übertroffen. Auch die Meeresoberflächen sind ungewöhnlich warm. Der Blick auf die nächsten Monate bietet weiteren Anlass zur Sorge. Und das Robert-Koch-Institut warnt vor Gesundheitsrisiken.

Für die Gesundheit ist Hitze ein Risiko. Und auch für die Einnahme bestimmter Medikamente kann sie zur Gefahr werden. Wie das RKI berichtet, sind einige Mittel besonders betroffen.
Die Zahl der infizierten Menschen ist auf 160 gestiegen. Legionellen werden häufig durch zerstäubtes Wasser in Duschen, Luftbefeuchtern oder Wasserhähnen übertragen.

In den ersten beiden Pandemiejahren war die Zahl der gemeldeten HIV-Fälle deutlich zurückgegangen. Für das Jahr 2022 meldet das Robert-Koch-Institut nun einen Anstieg.

Bundeskanzler Scholz steht vor der Koalitions-Klausur in Meseberg unter Druck, die EVG entscheidet über einen unbefristeten Bahnstreik und Rom kämpft gegen Ratten. Der F.A.Z. Newsletter.

Das West-Nil-Virus breitet sich hierzulande aus, die Tigermücke gründet immer mehr Populationen. Wie sich Gesundheitsforscher auf die neuen Klimawandel-Gefahren vorbereiten.

Im Berufungsprozess wegen eines möglichen Corona-Impfschadens hat das Oberlandesgericht Bamberg die Entscheidung vertagt. Der Senat will von einem Gutachter wissen, ob Astra-Zeneca auf mögliche Risiken hätte hinweisen müssen.

Zum ersten Mal hat bei „Germany’s Next Topmodel“ ein Curvy-Model gewonnen. Body Positivity ist in aller Munde. Aber in der Mode halten sich weiterhin klare Vorstellungen davon, was schön sein soll: dünne Körper.

Die US-Seuchenschutzbehörde CDC berichtet, dass viele Menschen an einer Fleischallergie leiden, dem Alpha-Gal-Syndrom. Diese wird durch Zeckenbisse verursacht und tritt auch in Deutschland auf.

Viele Corona-Maßnahmen haben während der Pandemie für Kritik und kontroverse Diskussionen gesorgt. Nun legt das Robert-Koch-Institut einen Bericht zur Wirksamkeit vor.

Vorerkrankte oder ältere Menschen kann Hitze schwer zu schaffen machen – bis hin zu einem vorzeitigen Tod. Im bisher wärmsten erfassten Sommer Europas gab es laut Schätzungen eines Forschungsteams mehr als 60.000 hitzeassoziierte Todesfälle.

Hitzerekorde purzeln, Warnungen häufen sich. Was bringt der Nationale Hitzeschutzplan? Klar ist: Viele der gesundheitlich am meisten Gefährdeten wissen nichts über ihre Risiken.

In Ulm beginnt der Mordprozess um die Tötung einer 14-Jährigen in Illerkirchberg, Leipzig fürchtet nach dem Urteil gegen Lina E. Ausschreitungen Linksextremer und die Eintracht will den DFB-Pokal nach Frankfurt holen. Der F.A.Z.- Newsletter